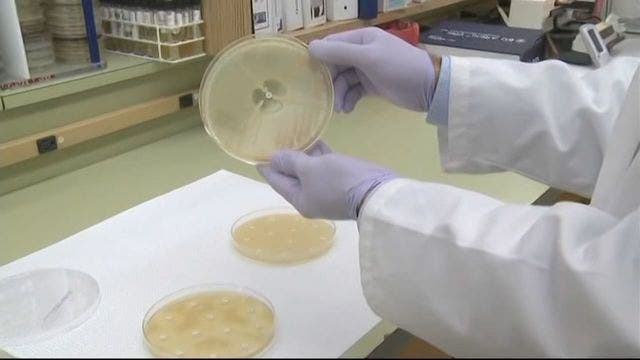
FDA OKs 1st drug to treat smallpox, in case of terror attack

FDA OKs 1st drug to treat smallpox, in case of terror attack
U.S. regulators have approved the first treatment for smallpox - a deadly disease that was wiped out four decades ago - in case the virus is used in a terror attack.
U.S. regulators have approved the first treatment for smallpox - a deadly disease that was wiped out four decades ago - in case the virus is used in a terror attack.
Nickelodeon announces new 'Rugrats' episodes, movie
Nickelodeon and Paramount Pictures have announced the animated children's series "Rugrats" is returning to the network with 26 episodes. The creators of the series will be executive producers.
Nickelodeon and Paramount Pictures have announced the animated children's series "Rugrats" is returning to the network with 26 episodes. The creators of the series will be executive producers.
Chick-fil-A is opening its first location in Hawaii
The Aloha State is getting their very own Chick-fil-A.
The Aloha State is getting their very own Chick-fil-A.
Officer's son learns sports injury is actually rare cancer
For 18-year-old Noah Holloway, this summer was supposed to be about spending time on the lake with friends - but he was diagnosed with a rare form of cancer.
For 18-year-old Noah Holloway, this summer was supposed to be about spending time on the lake with friends - but he was diagnosed with a rare form of cancer.
Build-A-Bear "Pay Your Age" sale is back for birthdays only
Houstonians witnessed last week's Build-A-Bear's "Pay Your Age" sale fiasco, but now the company has announced you can still get the age deal, "sort of" with its birthday-month "Count Your Candles" program.
Houstonians witnessed last week's Build-A-Bear's "Pay Your Age" sale fiasco, but now the company has announced you can still get the age deal, "sort of" with its birthday-month "Count Your Candles" program.
IHOP celebrates birthday with 60-cent pancakes
IHOP is celebrating its birthday with a sweet deal.
IHOP is celebrating its birthday with a sweet deal.
FDA issues recall for blood pressure medication due to cancer risk
The U.S. Food and Drug Administration has issued a recall for several drugs used to treat high blood pressure and heart failure due to the risk of cancer.
The U.S. Food and Drug Administration has issued a recall for several drugs used to treat high blood pressure and heart failure due to the risk of cancer.
Cute overload: Photographer reunites Disney princess newborns one year later
A photographer in California transformed six youngsters into adorable Disney princesses in a photo shoot that's nothing short of magical!
A photographer in California transformed six youngsters into adorable Disney princesses in a photo shoot that's nothing short of magical!
Officers surprise young boy at his police-themed birthday party
A young boy got a fun treat after a pair of officers decided to show up at his birthday party.
A young boy got a fun treat after a pair of officers decided to show up at his birthday party.
Veteran walking across American for PTSD awareness
A Marine Corp veteran is on a mission to honor his brother and help veterans with mental illness with a long cross country journey.
A Marine Corp veteran is on a mission to honor his brother and help veterans with mental illness with a long cross country journey.
Former Delta flight attendant celebrates 102 birthday
One of Delta's first flight attendants celebrated a major milestone this week in Acworth, Georgia.
One of Delta's first flight attendants celebrated a major milestone this week in Acworth, Georgia.
DA: Mother charged after baby dies from drugs transmitted through breast milk
Authorities say a Bucks County mother has been charged after her 11-week-old baby died from a lethal combination of drugs transmitted through her breast milk.
Authorities say a Bucks County mother has been charged after her 11-week-old baby died from a lethal combination of drugs transmitted through her breast milk.
Bend, Oregon is home to the last 'Blockbuster' video store in the country
With the closure of two Blockbuster stores in Alaska, that means there's only one lone franchise carrying on the torch.
With the closure of two Blockbuster stores in Alaska, that means there's only one lone franchise carrying on the torch.
Baby girl dies after being left for 2+ hours in hot car
MEDINA, Ohio (AP) -- Police say a 6-month-old girl found unresponsive in a car at a park in Ohio and has died.
MEDINA, Ohio (AP) -- Police say a 6-month-old girl found unresponsive in a car at a park in Ohio and has died.
Coupon dispute prompts white CVS manager to call police on black woman: report
A black woman from Chicago said a CVS store manager called the cops on her for trying to use a coupon he didn’t recognize.
A black woman from Chicago said a CVS store manager called the cops on her for trying to use a coupon he didn’t recognize.
'Astonished' Bay Area eighth-grader offered D-I football scholarship
James Smiley just finished eighth grade and he already has a verbal offer to play Division I college football at Florida Atlantic University. He's the first Bay Area prospect to receive such an incredible invitation before high school.
James Smiley just finished eighth grade and he already has a verbal offer to play Division I college football at Florida Atlantic University. He's the first Bay Area prospect to receive such an incredible invitation before high school.
Woman survives 7 days at bottom of cliff after crash
BIG SUR, California (Fox 32 News) - A woman spent seven days injured and alone at the bottom of a California cliff after a car crash.
BIG SUR, California (Fox 32 News) - A woman spent seven days injured and alone at the bottom of a California cliff after a car crash.
Woman admits to killing her father after finding his child porn collection
A British woman was sentenced to nine years in prison on Wednesday after she confessed to killing her father and burying his body in the backyard of their home in 2006 after she discovered his collection of child pornography, including indecent images of herself
A British woman was sentenced to nine years in prison on Wednesday after she confessed to killing her father and burying his body in the backyard of their home in 2006 after she discovered his collection of child pornography, including indecent images of herself
'Weeds' in city's potted plants turn out to be actual weed; someone planted marijuana seeds
POWELL, Wyo. (AP) -- A Wyoming city has discovered its potted plants have literally gone to pot.
POWELL, Wyo. (AP) -- A Wyoming city has discovered its potted plants have literally gone to pot.
Texas sheriff's deputy with 'heart of gold' to donate kidney to man in need
A sheriff’s deputy in Texas plans to donate one of his kidneys to a man who has been having difficulty finding a match.
A sheriff’s deputy in Texas plans to donate one of his kidneys to a man who has been having difficulty finding a match.